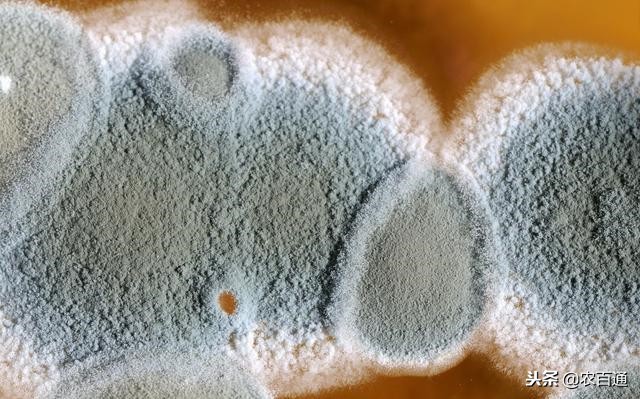
养殖正宗散养土鸡赚钱吗,容城散养土鸡养殖联系电话

学农技、找专家、问病害,关注“农百通”头条号,学习种养殖技术,专家在线帮助农民解决农业生产经营问题,促进农民增产增收。
一、散养土鸡雏鸡管理育雏期

鸡出壳 25 小时左右,开始喂食,将玉米渣或是小米作为饲料可以提高雏鸡啄食能力,三天后开始添加混合饲料;一般 6 周龄以内雏鸡,每日应饲喂 5、6 次,6 周龄以后,可以适当减少饲喂次数,通常一日饲喂 4~5 次,这一阶段的雏鸡消化系统还未发育完全,非常脆弱,所以一次进食不能过饱,饲喂应遵循少量多次原则;同时要提供干净和足够的水给雏鸡饮用,可以在温水中添加 5%的红糖供雏鸡饮用,这样可以促进雏鸡吸收体内剩余的蛋黄;时刻关注雏鸡的食量、健康情况,一般雏鸡食量突然下降或是增多都是疾病的先兆。
1、温度控制
适宜的温度,是雏鸡健康生长的关键,刚刚孵化的雏鸡,身上的羽毛较少,抗寒能力弱,各种器官发育未成熟,抵抗力不强,如果温度过低,很容易造成雏鸡感冒,影响食欲,甚至是直接导致死亡,大大降低雏鸡的成活率;温度过高,会导致雏鸡呼吸加快,带走体内过多的水分,雏鸡就会大量饮水,从而出现拉稀,严重损伤肠道。 所以在育雏期,温度控制很关键,雏鸡刚刚孵化时温度应保持在 34℃左右, 随后每周下降 3℃左右,5~6 周后即可脱温。 在保温过程,养殖户可以根据实际情况来选择保暖设备,常用的有保温箱、红外线等,不管哪种保暖方式,只要控制在适宜温度即可。
2、湿度管理
通常情况下,湿度在 63%左右最适宜雏鸡的生长 ,如果室内湿度较大,要增加垫料的更换次数,避免饮用水弄湿垫料,同时加强通风;如果过于干燥,可以增置加湿器或是采用人工洒水的方式增加湿度。
3、光照管理
雏鸡 1~2 日龄的时候, 采用 25 瓦的灯泡实施全天光照可以帮助其适应环境,尽快学会饮水、进食,此阶段的雏鸡对过亮和过暗的环境都不能适应,所以要严格控制光照的亮度;3~14 日龄阶段的雏鸡,只需在夜间喂食的时候打开照明设备,不用进行特殊光照, 这样可以保障雏鸡有良好的休息环境, 促进身体发育;在 14 日龄后,在晴朗和温暖的天气下可以将雏鸡放在室外活动半个小时,充足阳光可以促进钙的吸收,适当的运动可以增强雏鸡体制,提高免疫力。
二、土鸡放养的日常管理
1、散养场地的选择
土鸡散养的场地要远离人类的生活区和道路,同时要有充足的水源,通常选择有泉水的山坡最宜,既要保证阳光充足又要有阴凉的场地供土鸡休息。
2、定时定量补饲
虽然土鸡在散养阶段,可以在户外自行采食虫、草等作为饲料,但是这些饲料有限,营养不全面,不利于土鸡生长,一要定时定量的进行补饲,在夏季和秋季,杂草和昆虫较多 ,可以早晚各补一次。 但是春季和冬季野生饲料较少,补饲应该频繁些,大约三次,具体补饲次数根据散养环境情况来确定。
3、适当控制饮水
在夏季温度高,土鸡的饮水量会增加至食量的 3.5 倍,冬季温度低饮水量也会减少,一般情况下鸡喜欢喝常温水,所以夏季应该增加适合尺寸的饮水器,太深和太窄都不利于土鸡饮水,确保土鸡可以饮用足够的水, 同时还应设置阴凉的地方供土鸡休息。
4、预防兽害

近年来,先进的养殖技术已经大大提高土鸡的成活率,但是还会存在致命天敌,如老鹰、黄鼠狼、蛇等都会增加土鸡的死亡率,通常主要以预防为主,建立一个牢固的鸡舍 ,随时检查散养周围天敌出现情况,用网或是铁丝设置护栏,护栏出现破洞要及时补修。
5、及时对环境消毒
在普通舍养鸡过程中,仅仅需要对鸡舍进行消毒,但是散养的土鸡活动的场地范围很广,给消毒工作带来一定的困难,为确保土鸡健康成长,每周都应严格对场地进行杀菌消毒,采用多种消毒水轮流进行消毒。
三、疾病预防与控制
在土鸡养殖过程中,疾病主要以预防为主。 保证土鸡的成活率是土鸡养殖是否成功的关键点, 而疾病又是造成土鸡死亡的主要原因,在养殖过程中要得到好的经济效益,就必须对疾病进行控制和预防。
1、大肠杆菌
大肠杆菌病是土鸡养殖过程中最容易发生的疾病, 严重时会危及整个鸡群, 甚至全部死亡, 给养殖户造成严重的经济损失, 目前该病也是阻碍养殖业发展的一个因素。 预防大肠杆菌病,应从挑选种蛋开始,在挑选种蛋时,应选择干净无粪便污染,并进行严格消毒。 鸡群保持适合的密度,并加强通风,及时清除鸡粪,做好防鼠工作。
2、霉菌病
患霉菌病多发于两周内的雏鸡中,主要表现为食欲不振、呼吸困难、消瘦、无精打采,一旦出现疑似病情,应保持鸡舍干燥通风,并喂食制霉菌素。
【声明】本文来源于网络,由农百通整理发布,仅供参考,不对其真实性负责,如有侵权,请联系删除。